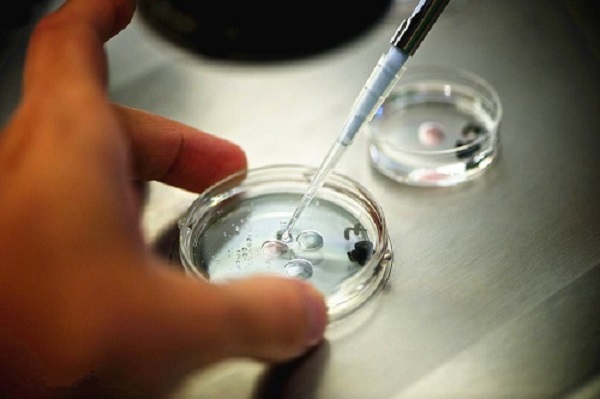
IVF

Building a family is one of life’s most meaningful journeys—but for many individuals and couples, the path to parenthood can be complex and emotionally challenging. we are dedicated to providing advanced IVF solutions that combine cutting-edge medical science, personalized care, and compassionate support to help growing families achieve their dreams.
A Science-Driven Approach to Fertility Care
In vitro fertilization (IVF) has transformed reproductive medicine, offering hope to those facing infertility, genetic concerns, or complex family-building circumstances. Our IVF programs are built on the latest advancements in reproductive technology, including:
By integrating medical innovation with proven clinical practices, we maximize success rates while prioritizing patient safety and well-being at every stage of treatment.

Personalized IVF Solutions for Every Family
No two fertility journeys are the same. That’s why we believe in tailored IVF treatment plans, designed around each patient’s medical history, goals, and personal circumstances. Whether you are:
Our experienced fertility specialists work closely with you to create a plan that aligns with your needs—medically, emotionally, and ethically.

Comprehensive Support Beyond the Clinic
Successful IVF treatment extends far beyond medical procedures. We offer end-to-end support services to ensure peace of mind throughout your journey, including:
Our multidisciplinary team is committed to walking beside you answering questions, addressing concerns, and celebrating milestones along the way.

Ethical, Safe, and Transparent Family Building
We are deeply committed to ethical fertility practices and international medical standards. Every IVF solution we offer is guided by principles of:
With advanced IVF solutions, experienced professionals, and compassionate guidance, [Your Company Name] is proud to support families from all walks of life. We understand that choosing IVF is a deeply personal decision, and we are honored to be part of your story.
The content is sourced from https://www.dyetexcorp.com/ and please attribute it when re-posting.

No responses yet